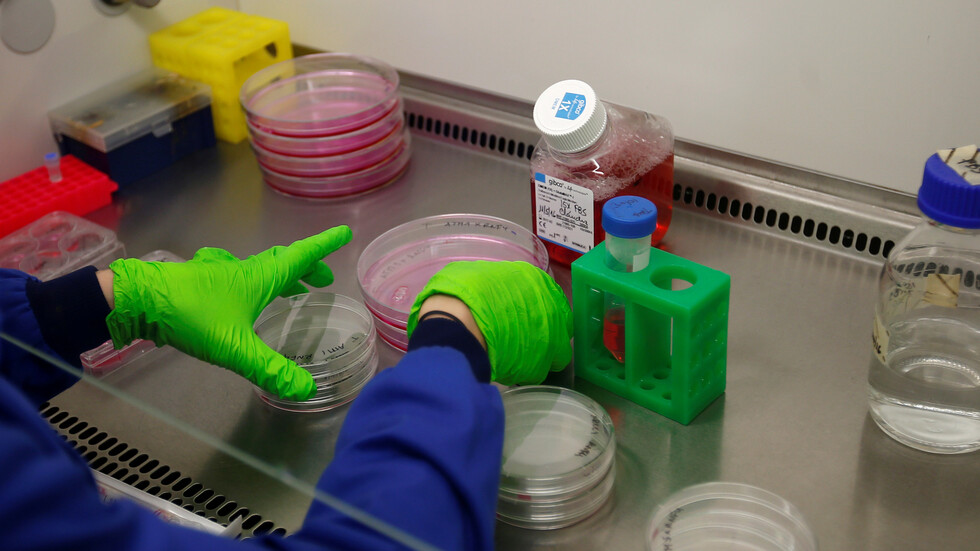
الكشف عن علامة موجودة لدى الرجال فقط تدل على الإصابة بسرطان الجلد

Stories
-
![اتفاق وقف إطلاق النار بين إسرائيل ولبنان]()
اتفاق وقف إطلاق النار بين إسرائيل ولبنان
RT STORIES
مصدر عسكري لبناني: إسرائيل شنت 64 غارة على الأراضي اللبنانية في يوم واحد
![مصدر عسكري لبناني: إسرائيل شنت 64 غارة على الأراضي اللبنانية في يوم واحد]() #اسأل_أكثر #Question_More
#اسأل_أكثر #Question_MoreRT STORIES
لحظة بلحظة.. تطورات الأوضاع في لبنان بعد تجدد القصف المتبادل
![لحظة بلحظة.. تطورات الأوضاع في لبنان بعد تجدد القصف المتبادل]() #اسأل_أكثر #Question_More
#اسأل_أكثر #Question_More![اتفاق وقف إطلاق النار بين إسرائيل ولبنان]() اتفاق وقف إطلاق النار بين إسرائيل ولبنان
اتفاق وقف إطلاق النار بين إسرائيل ولبنان
-
![مونديال 2026]()
مونديال 2026
RT STORIES
حادث أمني يثير القلق بالقرب من معسكر إنجلترا قبل انطلاق مونديال 2026
![حادث أمني يثير القلق بالقرب من معسكر إنجلترا قبل انطلاق مونديال 2026]() #اسأل_أكثر #Question_More
#اسأل_أكثر #Question_MoreRT STORIES
دلالات تعادل المغرب والنرويج قبل ضربة البداية في المونديال
![دلالات تعادل المغرب والنرويج قبل ضربة البداية في المونديال]() #اسأل_أكثر #Question_More
#اسأل_أكثر #Question_MoreRT STORIES
خطة سرية في لندن للاحتفال بتتويج إنجلترا بكأس العالم 2026
![خطة سرية في لندن للاحتفال بتتويج إنجلترا بكأس العالم 2026]() #اسأل_أكثر #Question_More
#اسأل_أكثر #Question_MoreRT STORIES
5 سنوات بعد معجزة اليورو.. إريكسن ينهار خلال مباراة منتخب بلاده أمام أوكرانيا (فيديو)
#اسأل_أكثر #Question_MoreRT STORIES
فيديو بين محمد صلاح وكارلو أنشيلوتي في مباراة مصر والبرازيل الودية يكتسح الإنترنت
![فيديو بين محمد صلاح وكارلو أنشيلوتي في مباراة مصر والبرازيل الودية يكتسح الإنترنت]() #اسأل_أكثر #Question_More
#اسأل_أكثر #Question_MoreRT STORIES
" ثعابين سامة" تثير الذعر بالقرب من مقر إقامة أحد منتخبات كأس العالم (فيديو - صورة)
![" ثعابين سامة" تثير الذعر بالقرب من مقر إقامة أحد منتخبات كأس العالم (فيديو - صورة)]() #اسأل_أكثر #Question_More
#اسأل_أكثر #Question_More![مونديال 2026]() مونديال 2026
مونديال 2026
-
![تبادل الضربات بين إسرائيل وإيران]()
تبادل الضربات بين إسرائيل وإيران
RT STORIES
الجيش الإسرائيلي يعلن تدمير منظومات دفاع استراتيجية إيرانية بهجوم جوي واسع (فيديو)
![الجيش الإسرائيلي يعلن تدمير منظومات دفاع استراتيجية إيرانية بهجوم جوي واسع (فيديو)]() #اسأل_أكثر #Question_More
#اسأل_أكثر #Question_MoreRT STORIES
الحرس الثوري يهدد دول المنطقة: اللعبة الخطيرة ستطال كل مواقع الطاقة
![الحرس الثوري يهدد دول المنطقة: اللعبة الخطيرة ستطال كل مواقع الطاقة]() #اسأل_أكثر #Question_More
#اسأل_أكثر #Question_MoreRT STORIES
أحدهما سعودي.. إعلام إيراني يطرح على طهران خيارين للرد على استهداف إسرائيل مصنع كارون للبتروكيماويات
![أحدهما سعودي.. إعلام إيراني يطرح على طهران خيارين للرد على استهداف إسرائيل مصنع كارون للبتروكيماويات]() #اسأل_أكثر #Question_More
#اسأل_أكثر #Question_MoreRT STORIES
تحول استراتيجي إسرائيلي.. البنية التحتية الإيرانية في خطر
![تحول استراتيجي إسرائيلي.. البنية التحتية الإيرانية في خطر]() #اسأل_أكثر #Question_More
#اسأل_أكثر #Question_MoreRT STORIES
"حنظلة" تعلن استهداف أنظمة الرادار الإسرائيلية وتوجه رسالة لـ "البعض"
!["حنظلة" تعلن استهداف أنظمة الرادار الإسرائيلية وتوجه رسالة لـ "البعض"]() #اسأل_أكثر #Question_More
#اسأل_أكثر #Question_MoreRT STORIES
مسؤول إيراني: غارة جوية على مركز عسكري في تبريز فجر اليوم
![مسؤول إيراني: غارة جوية على مركز عسكري في تبريز فجر اليوم]() #اسأل_أكثر #Question_More
#اسأل_أكثر #Question_MoreRT STORIES
الحوثيون يعلنون حظر الملاحة الإسرائيلية بشكل كامل في البحر الأحمر
![الحوثيون يعلنون حظر الملاحة الإسرائيلية بشكل كامل في البحر الأحمر]() #اسأل_أكثر #Question_More
#اسأل_أكثر #Question_MoreRT STORIES
إذاعة الجيش الإسرائيلي: تنفيذ موجتين من الهجمات على إيران (فيديو)
![إذاعة الجيش الإسرائيلي: تنفيذ موجتين من الهجمات على إيران (فيديو)]() #اسأل_أكثر #Question_More
#اسأل_أكثر #Question_MoreRT STORIES
إسرائيل تعلن استهداف مصنع بتروكيماويات جنوب غربي إيران
![إسرائيل تعلن استهداف مصنع بتروكيماويات جنوب غربي إيران]() #اسأل_أكثر #Question_More
#اسأل_أكثر #Question_MoreRT STORIES
تضرر 5 مبان في مستوطنة ايتمار جراء هجوم صاروخي إيراني (فيديو)
![تضرر 5 مبان في مستوطنة ايتمار جراء هجوم صاروخي إيراني (فيديو)]() #اسأل_أكثر #Question_More
#اسأل_أكثر #Question_MoreRT STORIES
"إسرائيل هيوم": معادلة جديدة تشكلت وتساؤلات بشأن الخطوة التالية ضد طهران
!["إسرائيل هيوم": معادلة جديدة تشكلت وتساؤلات بشأن الخطوة التالية ضد طهران]() #اسأل_أكثر #Question_More
#اسأل_أكثر #Question_MoreRT STORIES
إسرائيل وإيران تتبادلان الضربات .. لحظة بلحظة
![إسرائيل وإيران تتبادلان الضربات .. لحظة بلحظة]() #اسأل_أكثر #Question_More
#اسأل_أكثر #Question_MoreRT STORIES
مراسلتنا: إطلاق صواريخ من إيران نحو إسرائيل ورصد انفجارات في سماء القدس ورام الله (فيديو)
![مراسلتنا: إطلاق صواريخ من إيران نحو إسرائيل ورصد انفجارات في سماء القدس ورام الله (فيديو)]() #اسأل_أكثر #Question_More
#اسأل_أكثر #Question_MoreRT STORIES
إسرائيل تعلن بدء "حرب الرد" على إيران
![إسرائيل تعلن بدء "حرب الرد" على إيران]() #اسأل_أكثر #Question_More
#اسأل_أكثر #Question_MoreRT STORIES
السعودية.. سماع دوي انفجارات وبيان عاجل من منصة الإنذار المبكر في حالات الطوارئ
![السعودية.. سماع دوي انفجارات وبيان عاجل من منصة الإنذار المبكر في حالات الطوارئ]() #اسأل_أكثر #Question_More
#اسأل_أكثر #Question_MoreRT STORIES
مسؤول أمريكي: الضربات الإسرائيلية على إيران "محدودة النطاق" والجيش الأمريكي لم يشارك فيها
![مسؤول أمريكي: الضربات الإسرائيلية على إيران "محدودة النطاق" والجيش الأمريكي لم يشارك فيها]() #اسأل_أكثر #Question_More
#اسأل_أكثر #Question_MoreRT STORIES
مستشار خامنئي يوجه رسالة تحذيرية لواشنطن ويهدد بإغلاق مضيق باب المندب
![مستشار خامنئي يوجه رسالة تحذيرية لواشنطن ويهدد بإغلاق مضيق باب المندب]() #اسأل_أكثر #Question_More
#اسأل_أكثر #Question_MoreRT STORIES
إسرائيل تغلق معابر غزة عقب الهجمات الصاروخية الإيرانية حتى إشعار آخر
![إسرائيل تغلق معابر غزة عقب الهجمات الصاروخية الإيرانية حتى إشعار آخر]() #اسأل_أكثر #Question_More
#اسأل_أكثر #Question_MoreRT STORIES
"يديعوت أحرونوت": الجيش الإسرائيلي رصد حوالي أربع عمليات إطلاق صواريخ من إيران نحو إسرائيل
!["يديعوت أحرونوت": الجيش الإسرائيلي رصد حوالي أربع عمليات إطلاق صواريخ من إيران نحو إسرائيل]() #اسأل_أكثر #Question_More
#اسأل_أكثر #Question_MoreRT STORIES
الجيش الإسرائيلي: وابل جديد من الصواريخ من إيران باتجاه إسرائيل
![الجيش الإسرائيلي: وابل جديد من الصواريخ من إيران باتجاه إسرائيل]() #اسأل_أكثر #Question_More
#اسأل_أكثر #Question_MoreRT STORIES
بيان من مقر خاتم الأنبياء عن الهجوم الإيراني على إسرائيل ردا على قصف الضاحية
![بيان من مقر خاتم الأنبياء عن الهجوم الإيراني على إسرائيل ردا على قصف الضاحية]() #اسأل_أكثر #Question_More
#اسأل_أكثر #Question_MoreRT STORIES
"حنظلة الإيرانية": ننفذ الآن هجوما إلكترونيا ضد إسرائيل
!["حنظلة الإيرانية": ننفذ الآن هجوما إلكترونيا ضد إسرائيل]() #اسأل_أكثر #Question_More
#اسأل_أكثر #Question_MoreRT STORIES
الحرس الثوري الإيراني يكشف تفاصيل الهجوم الإيراني على إسرائيل
![الحرس الثوري الإيراني يكشف تفاصيل الهجوم الإيراني على إسرائيل]() #اسأل_أكثر #Question_More
#اسأل_أكثر #Question_MoreRT STORIES
موجات صاروخية إيرانية متتالية تضرب إسرائيل ردا على قصف الضاحية الجنوبية لبيروت (فيديوهات)
![موجات صاروخية إيرانية متتالية تضرب إسرائيل ردا على قصف الضاحية الجنوبية لبيروت (فيديوهات)]() #اسأل_أكثر #Question_More
#اسأل_أكثر #Question_MoreRT STORIES
ترامب في تصريح مفاجئ: أقول لإيران لقد أطلقتم صواريخكم على إسرائيل وهذا يكفي
![ترامب في تصريح مفاجئ: أقول لإيران لقد أطلقتم صواريخكم على إسرائيل وهذا يكفي]() #اسأل_أكثر #Question_More
#اسأل_أكثر #Question_MoreRT STORIES
ترامب لفوكس نيوز: لست سعيدا بوقوع الهجوم الإسرائيلي على بيروت
![ترامب لفوكس نيوز: لست سعيدا بوقوع الهجوم الإسرائيلي على بيروت]() #اسأل_أكثر #Question_More
#اسأل_أكثر #Question_MoreRT STORIES
ترامب لأكسيوس: سأتصل بنتنياهو الآن وأطلب منه عدم الرد على إيران
![ترامب لأكسيوس: سأتصل بنتنياهو الآن وأطلب منه عدم الرد على إيران]() #اسأل_أكثر #Question_More
#اسأل_أكثر #Question_MoreRT STORIES
زامير ينتظر "الضوء الأخضر" للرد ومسؤول إسرائيلي يقول: إسرائيل تستعد لهجوم قوي على إيران
![زامير ينتظر "الضوء الأخضر" للرد ومسؤول إسرائيلي يقول: إسرائيل تستعد لهجوم قوي على إيران]() #اسأل_أكثر #Question_More
#اسأل_أكثر #Question_MoreRT STORIES
بعد الهجوم الإيراني نتنياهو أمام أخطر اختبار: رد قاس أو ثمن سياسي باهظ
![بعد الهجوم الإيراني نتنياهو أمام أخطر اختبار: رد قاس أو ثمن سياسي باهظ]() #اسأل_أكثر #Question_More
#اسأل_أكثر #Question_MoreRT STORIES
مشاورات مصرية إيرانية بعد الهجوم على إسرائيل
![مشاورات مصرية إيرانية بعد الهجوم على إسرائيل]() #اسأل_أكثر #Question_More
#اسأل_أكثر #Question_MoreRT STORIES
عراقجي يبحث مع نظرائه في فرنسا وبريطانيا وتركيا وقائد الجيش الباكستاني قصف إيران لإسرائيل
![عراقجي يبحث مع نظرائه في فرنسا وبريطانيا وتركيا وقائد الجيش الباكستاني قصف إيران لإسرائيل]() #اسأل_أكثر #Question_More
#اسأل_أكثر #Question_MoreRT STORIES
"خاتم الأنبياء" يتوعد إسرائيل: ردنا سيكون مدمرا في حال قصفتم إيران.. سنوجه ضربة ساحقة لتل أبيب
!["خاتم الأنبياء" يتوعد إسرائيل: ردنا سيكون مدمرا في حال قصفتم إيران.. سنوجه ضربة ساحقة لتل أبيب]() #اسأل_أكثر #Question_More
#اسأل_أكثر #Question_MoreRT STORIES
النفط يقفز بأكثر من 3% مع تصاعد التوتر بين إسرائيل وإيران
![النفط يقفز بأكثر من 3% مع تصاعد التوتر بين إسرائيل وإيران]() #اسأل_أكثر #Question_More
#اسأل_أكثر #Question_MoreRT STORIES
عقب طلب ترامب بعدم الرد.. نتنياهو يبحث مع قادة الجيش الهجوم الصاروخي الإيراني على إسرائيل
![عقب طلب ترامب بعدم الرد.. نتنياهو يبحث مع قادة الجيش الهجوم الصاروخي الإيراني على إسرائيل]() #اسأل_أكثر #Question_More
#اسأل_أكثر #Question_More![تبادل الضربات بين إسرائيل وإيران]() تبادل الضربات بين إسرائيل وإيران
تبادل الضربات بين إسرائيل وإيران
-
![العملية العسكرية الروسية في أوكرانيا]()
العملية العسكرية الروسية في أوكرانيا
RT STORIES
القوات الروسية تقترب من أهم حصون قوات كييف في إقليم دونباس
![القوات الروسية تقترب من أهم حصون قوات كييف في إقليم دونباس]() #اسأل_أكثر #Question_More
#اسأل_أكثر #Question_MoreRT STORIES
الدفاع الروسية: إسقاط 510 مسيرات أوكرانية غربي البلاد
![الدفاع الروسية: إسقاط 510 مسيرات أوكرانية غربي البلاد]() #اسأل_أكثر #Question_More
#اسأل_أكثر #Question_MoreRT STORIES
زيلينسكي يشتكي من نقص أنظمة الدفاع الجوي في أوكرانيا
![زيلينسكي يشتكي من نقص أنظمة الدفاع الجوي في أوكرانيا]() #اسأل_أكثر #Question_More
#اسأل_أكثر #Question_MoreRT STORIES
مصدر روسي: تدمير 3 مواقع عسكرية محصنة شمال أوكرانيا
![مصدر روسي: تدمير 3 مواقع عسكرية محصنة شمال أوكرانيا]() #اسأل_أكثر #Question_More
#اسأل_أكثر #Question_More![العملية العسكرية الروسية في أوكرانيا]() العملية العسكرية الروسية في أوكرانيا
العملية العسكرية الروسية في أوكرانيا
-
![فيديوهات]()
فيديوهات
RT STORIES
إيرانيون يشاهدون صواريخ منطلقة صوب إسرائيل أثناء تجمع حاشد غربي البلاد
![إيرانيون يشاهدون صواريخ منطلقة صوب إسرائيل أثناء تجمع حاشد غربي البلاد]() #اسأل_أكثر #Question_More
#اسأل_أكثر #Question_MoreRT STORIES
مراسم عسكرية تكريما لجنرال لبناني قتل في غارة جوية إسرائيلية
![مراسم عسكرية تكريما لجنرال لبناني قتل في غارة جوية إسرائيلية]() #اسأل_أكثر #Question_More
#اسأل_أكثر #Question_More![فيديوهات]() فيديوهات
فيديوهات
دراسة: السمنة تزيد من البقاء على قيد الحياة في الحالات المتقدمة من سرطان يصيب الرجال
توصلت دراسة جديدة إلى أن مرضى السمنة المصابين بنوع متقدم من سرطان البروستات يعيشون لفترة أطول من المرضى الذين يعانون من زيادة الوزن والوزن الطبيعي.

وتابعت الدراسة أكثر من 1500 مريض على مدى ثلاث سنوات، وكان معدل البقاء على قيد الحياة لدى أولئك المصنفون على أنهم يعانون من السمنة، مع مؤشر كتلة الجسم أكثر من 30، أعلى بنسبة 10% من المرضى النحيفين على مدى 36 شهرا.

سرطان الجلد: ثمانية علامات رئيسية تحذر من أن الشامة قد تكون سرطانية!
وعلى الرغم من أن السمنة ترتبط عادة بزيادة خطر الوفاة من العديد من أنواع السرطان وبعض الأمراض المزمنة الأخرى، إلا أن هناك بعض الأدلة في عدد قليل من أنواع السرطان على ميزة البقاء على قيد الحياة للمرضى الذين يعانون من ارتفاع مؤشر كتلة الجسم. وتُعرف هذه الظاهرة باسم "مفارقة السمنة".
ومفارقة السمنة هي فرضية طبية تنص على أن السمنة (وارتفاع الكوليسترول، عند استخدام الاصطلاح الأشمل لعلم الأوبئة العكسي) قد تكون على نحو غير متوقع وقائية ومرتبطة بارتفاع معدل البقاء على قيد الحياة لدى مجموعات معينة من الأشخاص.
وأراد نيكولا فوساتي وألبرتو مارتيني وزملاؤه في جامعة سان رافاييل في إيطاليا، اختبار ما إذا كانت "مفارقة السمنة" تنطبق على مرضى سرطان البروستات النقيلي المقاوم للإخصاء، وهو شكل متقدم من المرض لم يعد يستجيب للعلاجات الخافضة لهرمون التستوستيرون.
ودرسوا معدلات البقاء على قيد الحياة في 1577 مريضا شاركوا في ثلاث تجارب سريرية مختلفة، بمتوسط عمر 69 ومتوسط مؤشر كتلة الجسم 28.
ووجدوا أن مؤشر كتلة الجسم كان عاملا وقائيا في كل من البقاء على قيد الحياة بشكل عام وخاصة بالسرطان، مع احتمالية بقاء أعلى بنسبة 4% واحتمالية بقاء خاصة بالسرطان بنسبة 29%. حتى عندما تم تعديلهم لجرعات أعلى من العلاج الكيميائي الممنوح للمرضى، وجد الفريق أن التأثير الوقائي بقي قائما.
وعلى مدى 36 شهرا، نجا نحو 30% من مرضى السمنة مقارنة بـ 20% من الذين يعانون من زيادة الوزن والوزن الطبيعي.
ويقول الدكتور نيكولا فوساتي، أخصائي المسالك البولية في جامعة سان رافاييل: "بالنظر إلى المرضى الذين يعانون من ورم خبيث لسرطان البروستات، وجدنا أن المرضى الذين يعانون من السمنة المفرطة يعيشون لفترة أطول. وهذا يعني أنه يمكن استخدام مؤشر كتلة الجسم للتنبؤ بالبقاء على قيد الحياة لدى هؤلاء المرضى".
الكشف عن علامة موجودة لدى الرجال فقط تدل على الإصابة بسرطان الجلد
وأضاف: "لوحظت مفارقة السمنة هذه في بعض أنواع السرطان الأخرى، ربما بسبب العلاقة بين دهون الأنسجة وجينومات السرطان، وهناك حاجة إلى مزيد من البحث في هذا المجال. ومن الممكن أيضا أن يكون تحسين البقاء على قيد الحياة ناتجا عن تفاعل العلاج الكيميائي مع الأدوية الأخرى، حيث يميل مرضى السمنة في هذه الفئة العمرية الأكبر سنا إلى تناول الأدوية لحالات أخرى ولا نفهم تماما كيف تترابط هذه الأدوية".
وتابع: "مع ذلك، لا نوصي بزيادة الوزن لأي شخص مصاب بهذا المرض أو غيره. فالسمنة عامل خطر للعديد من السرطانات والأمراض الأخرى، ويجب أن يسعى المرضى دائما إلى الحصول على مؤشر كتلة جسم صحي من 18 إلى 24".
وأشار البروفيسور بيتر ألبرز، من جامعة دوسلدورف: "هناك العديد من التفسيرات المحتملة للارتباط بين وزن الجسم والنتائج الإيجابية في السرطانات النقيلية. وقد يكون المرضى الذين يعانون من ارتفاع مؤشر كتلة الجسم قادرين على تحمل سمية العلاجات وآثارها الجانبية أفضل؛ في سرطان البروستات قد يكون ذلك بسبب التأثير الوقائي للهرمونات الموجودة في دهون الأنسجة، ومن المعروف أن الرجال الأصحاء الذين لديهم مؤشر كتلة جسم أعلى بقليل لديهم متوسط عمر أعلى مقارنة بالأشخاص النحيفين للغاية. ومع ذلك، في الوقت الحالي، هذه مجرد فرضيات. وهناك حاجة إلى مزيد من البحث لتحديد الآلية البيولوجية وراء هذه النتائج المختلفة. وحتى يتم إثبات هذه الآلية، لا يمكننا التوصية بأي تغيير في العلاج للمرضى المصابين بسرطان البروستات المتقدم".
المصدر: ميديكال إكسبريس























































































































































التعليقات